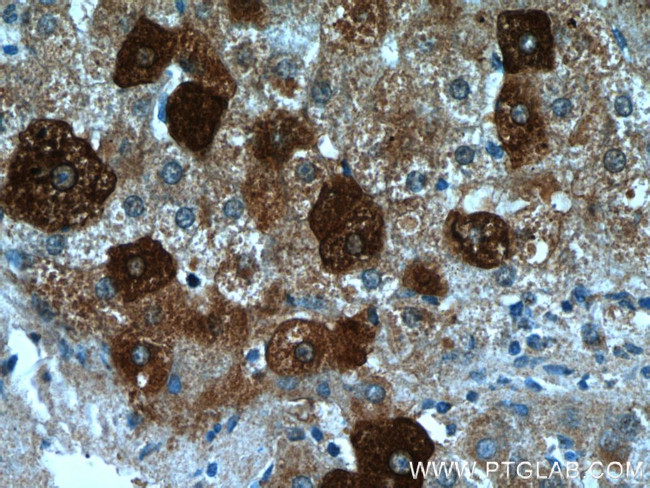
FUCA1 Antibody in Immunohistochemistry (Paraffin) (IHC (P))

Search
Proteintech
FUCA1 Polyclonal Antibody
{{$productOrderCtrl.translations['antibody.pdp.commerceCard.promotion.promotions']}}
{{$productOrderCtrl.translations['antibody.pdp.commerceCard.promotion.viewpromo']}}
{{$productOrderCtrl.translations['antibody.pdp.commerceCard.promotion.promocode']}}: {{promo.promoCode}} {{promo.promoTitle}} {{promo.promoDescription}}. {{$productOrderCtrl.translations['antibody.pdp.commerceCard.promotion.learnmore']}}
产品信息
16420-1-AP
种属反应
已发表种属
宿主/亚型
分类
类型
抗原
偶联物
形式
浓度
规格
纯化类型
保存液
内含物
保存条件
运输条件
产品详细信息
Immunogen sequence: EEWADLFQA AGAKYVVLTT KHHEGFTNWP SPVSWNWNSK DVGPHRDLVG ELGTALRKRN IRYGLYHSLL EWFHPLYLLD KKNGFKTQHF VSAKTMPELY DLVNSYKPDL IWSDGEWECP DTYWNSTNFL SWLYNDSPVK DEVVVNDRWG QNCSCHHGGY YNCEDKFKPQ SLPDHKWEMC TSIDKFSWGY RRDMALSDVT EESEIISELV QTVSLGGNYL LNIGPTKDGL IVPIFQERLL AVGKWLSING EAIYASKPWR VQWEKNTTSV WYTSKGSAVY AIFLHWPENG VLNLESPITT STTKITMLGI QGDLKWSTDP DKGLFISLPQ LPPSAVPAEF AWTIKLTGVK (113-461 aa encoded by BC017338)
靶标信息
Alpha-L-fucosidase (EC 3.2.1.51) is a lysosomal enzyme involved in the degradation of fucose-containing glycoproteins and glycolipids (Occhiodoro et al., 1989 [PubMed 2803312]). At least 2 separate polymorphic alpha-L-fucosidases are recognized in man: that in tissues, FUCA1, which is deficient in fucosidosis (MIM 230000), and that in plasma, FUCA2 (MIM 136820).[supplied by OMIM].
仅用于科研。不用于诊断过程。未经明确授权不得转售。
生物信息学
蛋白别名: A L fucosidase I; A L fucoside fucohydrolase 1; a-L-fucosidase 1; alpha-L fucosidase; Alpha-L-fucosidase 1; Alpha-L-fucosidase I; alpha-L-fucosidase precursor (EC 3.2.1.5); Alpha-L-fucoside fucohydrolase 1; EC 3.2.1; EC 3.2.1.51; Fucosidase alpha-L-1 tissue; fucosidase, alpha-L- 1, tissue; Fucosidase, alpha-L-1, tissue; I+/--L-fucosidase 1; Tissue alpha-L-fucosidase; tissue fucosidase; Tissue α L fucosidase; unnamed protein product; α L fucosidase 1; α L fucosidase I; α L fucoside fucohydrolase 1
基因别名: 0610006A03Rik; 9530055J05Rik; Afuc; FUCA; FUCA1; Nbla10230
UniProt ID: (Human) P04066, (Rat) P17164, (Mouse) Q99LJ1
Entrez Gene ID: (Human) 2517, (Rat) 24375, (Mouse) 71665